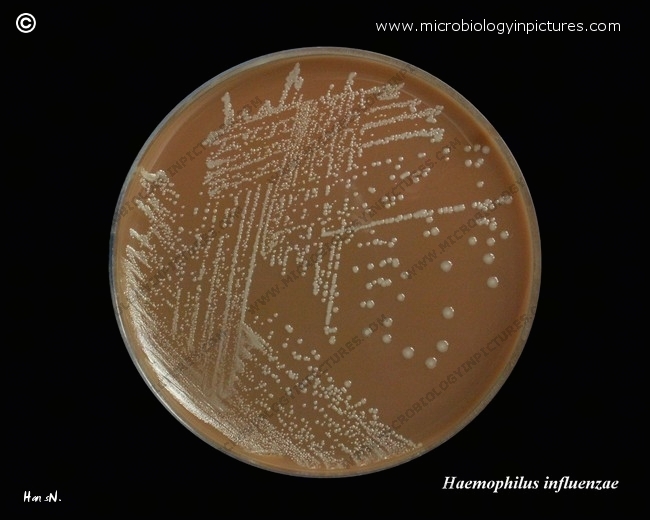

Haemophilus influenzae cultivated on chocolate agar. Cultivation 24 hours, 37 °C in an aerobic atmosphere enriched with 5% carbon dioxide.
Haemophilus influenzae may have a polysaccharide capsule. Capsulate Haemophilus influenzae are divided into six serotypes, a-f, based on the capsular polysaccharide antigen. These surface polysaccharides are strongly associated with virulence, particularly in type b H.influenzae, which is responsible for most cases of serious infections.
